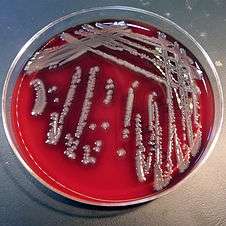

Aeromonas hydrophila
| Aeromonas hydrophila | |
|---|---|
![]() | |
| Scientific classification | |
| Domain: | Bacteria |
| Kingdom: | Proteobacteria |
| Phylum: | Gammaproteobacteria |
| Class: | Aeromonadales |
| Genus: | Aeromonas |
| Species: | A. hydrophila |
| Binomial name | |
| Aeromonas hydrophila (Chester, 1901) Stanier, 1943 | |
| Synonyms | |
|
Bacillus hydrophilus fuscus Sanarelli 1871 | |
Aeromonas hydrophila is a heterotrophic, Gram-negative, rod-shaped bacterium mainly found in areas with a warm climate. This bacterium can be found in fresh or brackish water. It can survive in aerobic and anaerobic environments, and can digest materials such as gelatin and hemoglobin. A. hydrophila was isolated from humans and animals in the 1950s. It is the most well known of the species of Aeromonas. It is resistant to most common antibiotics and cold temperatures and is oxidase and indole positive.
Structure
A. hydrophila bacteria are Gram-negative, straight rods with rounded ends (bacilli to coccibacilli shape) usually from 0.3 to 1.0 μm in width, and 1.0 to 3.0 μm in length. They can grow at temperatures as low as 4 °C. These bacteria are motile by a polar flagellum.
Pathology
Because of its structure, it is very toxic to many organisms. When it enters the body of its victim, it travels through the bloodstream to the first available organ. It produces aerolysin cytotoxic enterotoxin that can cause tissue damage. A. hydrophila, A. caviae, and A. sobria are all considered to be opportunistic pathogens, meaning they rarely infect healthy individuals. A. hydrophila is widely considered a major fish and amphibian pathogen,[1] and its pathogenicity in humans has been recognized for decades.[2] The genomic insights of aeromonads could be a stepping stone into understanding of them[3]
Pathogenic mechanism
The pathogenicity of Aeromonas species was believed to be mediated by a number of extracellular proteins such as aerolysin, lipase, chitinase, amylase, gelatinase, hemolysins, and enterotoxins. However, the pathogenic mechanisms are unknown. The recently proposed type-III secretion system (TTSS) has been linked to Aeromonas pathogenesis. TTSS is a specialized protein secretion machinery that exports virulence factors directly to host cells. These factors subvert normal host cell functions to the benefit of invading bacteria. In contrast to the general secretory pathway, the TTSS is triggered when a pathogen comes in contact with host cells. ADP-ribosylation toxin is one of the effector molecules secreted by several pathogenic bacteria and translocated through the TTSS and delivered into the host cytoplasm, which leads to interruption of the NF-κB pathway, cytoskeletal damage, and apoptosis. This toxin has been characterized in A. hydrophila (human diarrhoeal isolate), A. salmonicida (fish pathogen), and A. jandaei GV17, a pathogenic strain which can cause disease both in humans and fish.
Occurrence of exposure
A. hydrophila infections occur most often during environmental changes, stressors, changes in temperature, in contaminated environments, and when an organism is already infected with a virus or another bacterium. It can also be ingested through food products contaminated with the bacterium, such as seafood, meats, and even certain vegetables such as sprouts. It can also be transmitted by leeches.[4]
Fish and amphibians
A. hydrophila is associated with diseases mainly found in freshwater fish and amphibians, because these organisms live in aquatic environments. It is linked to a disease found in frogs called red leg, which causes internal, sometimes fatal hemorrhaging. When infected with A. hydrophila, fish develop ulcers, tail rot, fin rot, and hemorrhagic septicemia. Hemorrhagic septicaemia causes lesions that lead to scale shedding, hemorrhages in the gills and anal area, ulcers, exophthalmia, and abdominal swelling.
Human diseases
A. hydrophila is not as pathogenic to humans as it is to fish and amphibians. One of the diseases it can cause in humans, gastroenteritis, occurs mostly in young children and people who have compromised immune systems or growth problems. This bacterium is linked to two types of gastroenteritis. The first type is a disease similar to cholera, which causes rice-water diarrhea. The other type is dysenteric gastroenteritis, which causes loose stools filled with blood and mucus. Dysenteric gastroenteritis is the most severe out of the two types, and can last for several weeks. A. hydrophila is also associated with cellulitis. It also causes diseases such as myonecrosis and eczema in people with compromised or suppressed (by medication) immune systems.[5] In very rare cases, A. hydrophila can cause necrotizing fasciitis.[6]
Outbreaks
Though A. hydrophila can cause serious disease, large scale outbreaks have not been reported. Outbreaks among vertebrates have occurred. One such incident occurred in Puerto Rico inside the intestinal tracts of lizards.[7] Some 116 different strains were found in the lizards. On May 1, 1988, a small outbreak happened in California. The 225 isolates in 219 patients caused their hospital admissions. Confidential morbidity report cards were used to report the cases to the local health departments. Investigations were conducted, and reports were sent to the California Department of Health Services for diagnosis and methods in treatment.
Treatments
A. hydrophila can be eliminated using a 1% sodium hypochlorite solution or 2% calcium hypochlorite solution.
Brage et al., 1990 recommends fluoroquinolone administration as a prophylactic treatment during medicinal leech application.[8]
Antibiotics such as chloramphenicol, florfenicol, tetracycline, sulfonamide, nitrofuran derivatives, and Pyridinecarboxylic acids are used to eliminate and control the infection of A. hydrophila.
Terramycin is placed in fish food during hatchery operations as another chemotherapeutic agent in preventing A. hydrophila.
References
- ↑ Prevalence and distribution of Aeromonas hydrophila in the United States
- ↑ Clinical and microbiological features of Aeromonas hydrophila-associated diarrhea
- ↑ Tan, Wen-Si; Yin, Wai-Fong; Chan, Kok-Gan (2 Jan 2015). "Insights into the Quorum-Sensing Activity in Aeromonas hydrophila Strain M013 as Revealed by Whole-Genome Sequencing". GenomeA. 3 (1): 1–2. doi:10.1128/genomeA.01372-14.
- ↑ Snower, DP; Ruef, C; Kuritza, AP; Edberg, SC (1989). "Aeromonas hydrophila infection associated with the use of medicinal leeches". J. Clin. Microbiol. 27: 1421–2. PMC 267578
. PMID 2666448. - ↑ Evolving concepts regarding the genus Aeromonas: an expanding panorama of species, disease presentations, and unanswered questions
- ↑ Necrotizing fasciitis caused by Aeromonas hydrophila
- ↑ Fulton, MacDonald. "The Bacterium Aeromonas hydrophila from Lizards of the genus Anolis in Puerto Rico". Archived October 31, 2004, at the Wayback Machine. Louisiana State University Medical Center, New Orleans.
- ↑ Braga A, Lineaweaver WC, Whitney TM, Follansbee S, Buncke HJ. Sensitivities of aerononas hydrophila cultured from medicinal leeches to oral antibiotics. J Reconstr Microsurg. 1990; 6(2):135-137
Further reading
- Hayes, John. Aeromonas hydrophila Oregon State University.
- Arrow Scientific. Aeromonas hydrophila
- "Aeromonas hydrophila." Bad Bug Book Foodborne Pathogenic Microorganisms and Natural Toxins Handbook. US Food and Drug Administration.
- "Aeromonas hydrophila and Related Bacteria." International Specialty Supply.
- "Georgia woman with flesh-eating disease leaves hospital"
External links
- Aeromonas hydrophila ATCC7966
- Type strain of Aeromonas hydrophila at BacDive - the Bacterial Diversity Metadatabase
